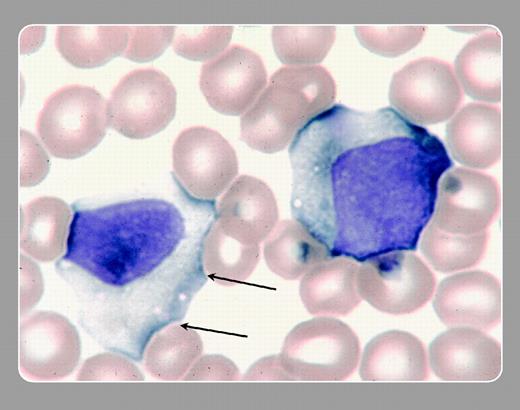
Peter Maslak and Susan McKenzie, Memorial Sloan-Kettering Cancer Center

Topics:
infectious mononucleosis
Large, irregular, atypical lymphocytes are seen in the peripheral blood of this patient with infectious mononucleosis. The indentation of the cytoplasm of the lymphocyte (arrows) by the red blood cells gives rise to the socalled “Dutch skirt” appearance to the border.FIG1
Peter Maslak and Susan McKenzie, Memorial Sloan-Kettering Cancer Center
Peter Maslak and Susan McKenzie, Memorial Sloan-Kettering Cancer Center
The above image was first published in the ASH IMAGE BANK, a reference and teaching tool that is continually updated with new atlas images and images of case studies. For more information or to contribute to the Image Bank, visit www.ashimagebank.org.
Copyright © 2004 by The American Society of Hematology
2004
This feature is available to Subscribers Only
Sign In or Create an Account Close Modal